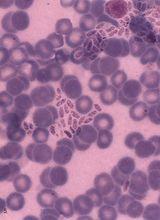

疾病分類
(1)犬絛蟲(犬復孔I象蟲、瓜實絛蟲):

蟲體呈淡紅色,長 10—50厘米。成熟體節長7亳米,寬2—3毫米,呈長卵圓形,外觀如黃瓜籽狀。每個成熟節片含兩套雌雄生殖器官,生殖孔開口於體節兩側的中央部。蚤類及犬毛虱為犬絛蟲的中間宿主,在其體內發育為似囊尾蚴。終宿主吞食了含似囊尾蚴的蚤或虱而被感染,在小腸內約經3周發育為成蟲。
(2)線中絛蟲(中線絛蟲):

蟲體長30~250厘米,最寬處為3毫米。成熟節片近方形,每節有一套生殖器官,子宮位於節片中央而呈縱的長囊狀,故眼觀該種絛蟲的鏈體中央部似有一縱線貫穿。已知中線絛蟲需兩個中間宿主,第一中間宿主為食糞的地蟎,在其體內形成似囊尾蚴。第二中間宿主為蛇、蛙、鳥類及嚙齒類,在它們體內形成四槽蚴,多在第二中間宿主的腹腔或肝、肺等器官內發現。四槽蚴被終宿主吞食後,經 16~20天變為成蟲。
(3)泡狀帶絛蟲(邊緣絛蟲):
蟲體長75~500厘米,前部節片寬而短,向後節片逐漸加長,成熟體節長寬為10~14毫米*4~5毫米。子宮有5~10對大側枝再分小枝,每個節片有一套生殖器官,生殖孔在節片一側不規則地互動開口。中間宿主為牛、羊、豬等家畜,幼蟲為細頸囊尾蚴,寄生在中間宿主的肝臟、大網膜及腸系膜等處,犬吞食含細頸囊尾蚴的內臟而被感染,經36~73日在小腸發育為成蟲。
(4)豆狀帶絛蟲(鋸齒絛蟲):

蟲體長60~200厘米,生殖孔不規則地在節片一側互動開口,稍突出,使蟲體側緣呈鋸齒狀。成熟體節長寬為10~15毫米*4~7毫米。子宮有8~14對側枝。中間宿主為家兔和野兔,幼蟲為豆狀囊尾蚴,寄生於兔的肝臟、網膜、腸系膜等處。犬吞食含豆狀囊尾蚴的內臟,經 35~46日發育為成蟲.
(5)多頭帶絛蟲(多頭絛蟲):
蟲體長40—100厘米,最寬處為5毫米,子宮有9—26對側枝。中間宿主為牛和羊,幼蟲為多頭蚴(腦共尾蚴),寄生於中間宿主腦內,有時也見於延腦或脊髓中。犬吞食含多頭蚴的腦而被感染,約經41—73天發育為成蟲。
(6)細粒棘球絛蟲:
蟲體由1個頭節和3~4個節片組成,全長不超過7毫米。成熟節片內有一套生殖器官,孕節長度超過蟲體全長的一半,子宮呈囊狀,沒有側枝,只有一些突起。細粒棘球絛蟲的幼蟲為棘球蚴,寄生於多種動物和人的肝、肺及其他器官中,犬吃了含棘球蚴的臟器而被感染。
(7)曼氏迭宮絛蟲(孟氏裂頭絛蟲):
蟲體長約100厘米,寬2~2.5厘米。頭節呈指形,背腹各有一個縱行的吸槽。頸節細長。節片一般寬大於長。孕卵節片則長寬幾乎相等。成熟節片中有一套生殖器官,節片前部中央有一圓形雄性生殖孔,子宮呈螺鏇盤曲,位於節片中部,子宮末端開口與陰道口分別位於雄性生殖孔下方。
蟲體呈黃灰色,體節中央因子宮與蟲卵而呈灰黑色點狀連線;曼氏迭宮絛蟲需要兩個中間宿主:
第一中間宿主為淡水橈足類(如劍水蚤),在其體內發育為原尾蚴。
第二中間宿主為蛙類和蛇類(魚類、鳥類甚至人可作為轉運宿主),在其體內發育為裂頭蚴。貓、犬為終末宿主,裂頭蚴在其小腸內發育為成蟲。
病理生理
[致病作用]當蟲體在體內大量寄生時,蟲體頭部的小鉤和吸盤叮附在小腸黏膜上,引起腸黏膜損傷和腸炎,蟲體吸取機體大量的營養,給犬生長發育造成障礙;使機體營養不良、消瘦、貧血。蟲體在代射過程中,不斷分泌毒素,刺激機體,可出現神經症狀分蟲體在腸道中聚集成團,可造成腸阻塞、腸扭轉、腸套迭及腸穿孔等症狀。
臨床表現
[症狀]重度感染時,可出現腸卡他、腸炎、出血性腸炎症狀、嘔吐。當腸管逆蠕動蟲體可進入胃中,嘔吐時蟲體可隨胃內容物一同嘔出。糞便可見到大量脫落的節片。患犬可見有異嗜、進行性消瘦、營養不良、貧血、精神沉鬱。有的可見有神經症狀、抽搐、痙攣等症狀。
[診斷]根據肛門周圍粘有脫落的節片或糞便中有脫落的蟲體節片可以確診。實驗室糞便檢查,可在顯微鏡下看到絛蟲卵加以判定。
疾病治療
(1)吡喹酮, 20毫克/千克體重,1次口服,隔5日再服1次。
(2)丙硫苯咪唑,10-15毫克/千克體重,1次/日,連服3日。
(3)滅絛靈,100毫克/千克體重,1次口服、
(4)甲苯咪唑,20毫克/千克體重,1次口服。
疾病預防
(1)治療性驅蟲;用氫溴酸檳榔素,用量為1.5~2毫克/千克體重,口服。使病犬絕食12~20小時後給藥。為了防止嘔吐,應在服藥前15—20分鐘給予稀碘酊液(水10毫升,碘酊兩滴)。或用吡喹酮,用量為5~10毫克/千克體重·次,口服。或用鹽酸丁萘脒,用量為25—50毫克/千克體重,1次口服,驅除細粒棘球絛蟲用50毫克,間隔48小時再用1次。
(2)預防性驅蟲:每年應進行4次預防性驅蟲(每季度1次),繁殖犬應在配種前3~4周內進行。驅蟲時應把犬隔離在一定範圍內,以便收集排出的蟲體和糞便,徹底銷毀,防止散布病原。春秋為高發期。

(3)注意清潔衛生,消滅傳染源:妥善處理屠宰廢棄物,防止犬採食帶有絛蟲蚴的中間宿主或其未煮熟的臟器,淡水魚及鼠類。保持犬舍和犬體清潔,經常用殺蟲劑殺滅犬體上的蚤與虱,消滅齧齒動物。